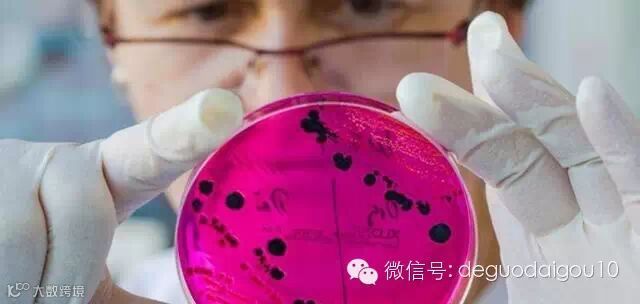

食品安全之于德国
我国食品界这些年来一直不太平,触目惊心的大案一个紧接一个,活生生的现实使人们已经失去了安全感。每天与毒物相伴,我们不知道什么是安全的?可靠的?可以放心食用的?
皮革奶,苏丹红,地沟油,三聚氰胺,毒馒头,瘦肉精,福喜过期烂肉……下一个是什么?
既然我们做的不好,今天我们就来图文并茂地看看人家德国的食品安全机制是如何工作的——绝对严进严出,全民监督;稍有疏忽,一家百年企业也可能被《食品法》告到宣告破产。不得不感慨,吃了这样优质的食品,不赢球才怪呢!
▌德国的食品安全的例子
说几个例子,亲身体验德国食品安全的严格:在德国买鸡蛋的时候,鸡蛋通常被装在硬纸盒里,整齐排列。硬纸盒大小不一,多是分6个或10个鸡蛋一盒,每个鸡蛋上都印有一串编号。这些编号就像是鸡蛋的“身份证”,根据它就可查出鸡蛋来自哪国、哪地、哪个饲养场、哪个鸡笼,母鸡饲养状况如何,是草鸡蛋还是普通饲养鸡蛋(分类从0到3)。编码就像鸡蛋的“身份证”。有了这些编码,鸡蛋质量只要有问题,有关部门就可以一直追查到饲养场或鸡笼。
曾经在超市中买过奶粉,但在付款的时候因为某种原因并未支付成功,只能放弃购买,店员只好对奶粉进行销毁处理,被告知因为奶粉为儿童食品,一旦从货架上取下,中间任何环境都有可能对奶粉的安全性造成威胁,所以不得不销毁处理。

在德国以动物食品为例,宰杀前,官方认可的兽医要对动物进行严格检查,合格后才发放宰杀许可证;屠宰后,要检查肉内是否有寄生虫、传染病毒等;进入生产车间检查更严更细,如哪一部分肉适合制作普通香肠,哪一部分适合制作火腿肠,香肠中加入食用香料和添加剂的含量以及肥肉和瘦肉的比例。无论是在屠宰场还是在食品加工厂,无论是在商店还是在运输过程中,食品必须处于冷冻状态,不新鲜的肉不允许上市出售。

在德国谷物类在制作前,食品评定机构首先要检查所使用的麦子在生长过程中用过什么农药和化肥,对人体是否有害;麦子入库前是否已去除了沙粒等杂物;在粮库内保存时的水分及温度是否符合规定的标准等;出库前,还要检查麦子是否存在发霉、发芽情况;在面粉加工厂,要检查加工过程是否符合有关规定;面包房的卫生条件和面包的质量更是检查的重点。层层的把关和检查,保证了德国商场里的面包安全。

如果一个人吃坏了肚子,并怀疑是食物的问题,可以随时拨打德国联邦消费者保护、食品与农业部设立的24小时免费投诉电话,“食品警察”会马上登门采样,并及时送到权威机构进行检测,并在第一时间把结果告知举报者。如果真是食物的问题,相关部门就会立即处理。

穆勒Müller是德国最大的面包制造商,这家有八十多年历史的著名家族企业因卫生问题陷入困境,巴伐利亚州地方食品卫生监督局在穆勒卫浴弗莱新县的生产车间发现了老鼠屎和蟑螂等,于是勒令其停产整顿,穆勒所有出产的面包等产品被召回,仅几天便损失数百万欧元,政府机构还要求其不能再自己的商店里销售自产面包。丑闻曝光后,德国大型廉价超市利德尔表示不再销售穆勒面包,之后,又有多家超市取消了合同,在多重困境下,这家德国最大的面包食品制造商宣布破产。
在德国生活过的朋友,如果喜欢吃坚果,对Seeberger这个坚果品牌绝对不会陌生,而同样是涉及到食品,Seeberger的所有坚果全部要取自天然坚果,绝不使用转基因食材,而且所有的采摘方式都采用传统的手工采摘,避免机器对食品造成污染或其他因素的破坏。

除了食品类,化妆品、家居用品、厨房清洁等,凡是与人体接触的产品,德国也都有严格的质量安全要求。
▌德国食品安全的成功原因
德国食品安全成功的法宝是确定了三大目标(保护消费者健康,仅允许提供质量可靠和符合安全标准的食品;保护消费者不受欺骗,严防欺诈;保护消费者知情权,提供的信息必须实事求是)和七项原则(食品链原则、企业责任原则、可追溯原则、独立而科学的风险评估原则、风险评估与风险管理分离原则、预防原则和风险沟通透明原则)。基于这些目标和原则,德国建立了一整套食品质量和安全管理体系。具体而言,有以下几个方面的特点:

一、法律法规完备:相关法律有德国法律,欧盟法律和国际法。
迄今,德国涉及食品立法及相关条例多达200余个。最基本的法律首推1879年制定的《食品法》,所列款项多达几十万条,贯穿食品生产和流通各个环节。其次是《食品和日用品管理法》明确规定了食品生产各个环节企业的责任,每个食品或饲料生产者,无论是农业经营者、面包师或食品添加材料制造商,都必须承担食品安全责任。

二、监管机制健全:单部管理、分级负责;政府督查与企业自律相结合;消费者积极参与监管
“单部管理、分级负责”原则,即各司其职,又相互协调配合。联邦一级由联邦食品、农业和消费者保护部负责,负责相关食品安全法律的制定;下设联邦消费者保护与食品安全局和联邦风险评估研究所,独立负责食品安全风险评估、然后提交风险管理部门;风险管理部门依照风险评估结果进行风险管理,负责食品安全事故的应急处理等。

“政府督查与企业自律相结合”原则,所有企业无论规模大小和行业差异均须进行食品安全自我监制,建立自我控制体系,都要执行食品危害与分析关键控制(HACCP)管理。所有食品生产企业都要在当地食品监管部门登记注册,履行记录所用原材料的质量、进货渠道和销售对象等信息的义务,对自己的产品进行自检,并随时接受主管部门的检查,承担召回责任。一旦发生问题,对于责任人要视情节和后果轻重进行处理,或被要求整改、罚款、封存或销毁货物、关闭企业,甚至付诸法律诉讼、追究刑事责任。
“消费者积极参与监管”原则,德国鼓励并引导消费者加强自身保护,积极主动参与食品安全监督。对于消费者投诉的任何问题食品,如卫生标准不合格或者食品标签有误,当地食品监督部门都必须受理并解决问题。如果发现买回家的食品在规定保质期限内出现变质现象,消费者业可向监管部门举报。代表消费者利益的德国消费者协会在保障食品质量和食品风险防范等方面更是发挥了重要作用。该协会设立的消费者咨询站遍及全德各地,负责免费向消费者提供食品安全信息咨询。

三、制度标准完善,对食品的包装、追溯、市场准入、安全标志有严格规定。
按照食品标示法规,在包装标示中必须标明生产者、生产流程、产地和企业名称、食品成分、保质期、认证标签等。
所谓可追溯制度实质上就是食品信息可追踪系统或食品在各个阶段信息流的连续性保障体系,食品的可追溯性从原材料进货开始,贯穿于生产、流通和消费各个环节。

市场准入包含两个方面:一是外国产品进入德国市场。凡欧盟以外国家生产的食品进入德国,均须在欧盟边境按照有关规定进行检疫检查,进入德国时要进行复检。如发现问题不能处理的要就地销毁;二是国内产品进入市场,要对食品生产和加工企业实行许可证制度,对食品出厂实行检验制度,对食品入市进行认证管理。

德国食品安全标准主要包括:食品生产标准、食品加工标准、产品标签标准和销售标准。其形成依据是:欧盟和国际通行标准、德国官方制定的适合国内需要的标准和德国非官方组织、机构、协会自行制定的标准。

四、信息透明:所有信息都会公开,起到监督作用。
在德国,食品从原材料采购到生产、加工、仓储、运输、销售各个环节都处于监控之下,各种信息通常都是公开透明的,且记录在案有据可查。一旦发现问题,便可追本溯源找到根源所在。一旦某食品问题严重,相关部门会通知媒体,对民众进行告诫,在一旦发生问题食品丑闻,各种媒体都会紧盯不放,竞相披露事件的来龙去脉和调查进展情况,既使得消费者由此得到更加详细和透明的信息,也客观上对政府起到监督和促进作用。
五、出现问题积极应对:态度决定未来,有错必纠。
德国也有过食品安全上的丑闻,但更多的是客观因素而非主观因素造成的,出现问题的企业也大多会及时接受处罚和进行改善,抱着敢于承担的态度。比如,德国之间出现过被污染的农产品从禽类扩展到猪肉类事件,导致10多万枚鸡蛋被销毁,数百头生猪被宰杀。通过追溯系统查出问题缘由;第一时间公布问题食品编号;迅速召回问题食品并销毁。
食品安全是头等大事,希望我们也能借鉴其长处,并改善我们的食品安全问题,让更多的人知道,让更多的人一起参与食品安全倡议中来,让我们的生活能够更加健康。


想了解更多舞台特效可以联系我们——广州市全亚贸易有限公司
欢迎你通过以下方式关注我们:
1、官网:http://www.chinaquanya.com/home.asp
2、联系电话:020-84601808
3、新浪微博:@广州市全亚贸易有限公司
4、通过微信扫描以下二维码添加:



